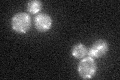
YGL083W
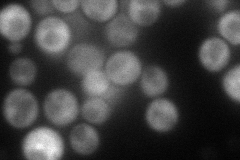
YGL083W
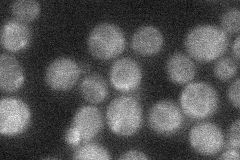
YGL083W
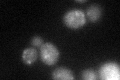
YGL083W
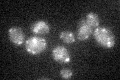
YGL083W

View description
Putative kinase, suppressor of GTPase mutant, similar to bovine rhodopsin kinase
Localization:
Intensity:
Fold change:
Significance:
-
C’ GFP library in SD
punctate25.22 -
N' NOP1pr-GFP in SD

cytosol83.5272 -
N' TEF2pr-mCherry in SD
cytosol92.6323 -
N' NATIVEpr-GFP in SD
below threshold21.3367 -
N' TEF2pr-VC and Cyto-VN in SD

cytosol46.2427 -
C’ GFP library in SD+DTT
punctate27.441.08No -
C’ GFP library in SD+H2O2

punctate25.080.99No -
C’ GFP library in Starvation Media
punctate24.020.95No -
C’ GFP library on the background of Pup2-DaMP

punctate -
C’ GFP library on the background of CCT mutant

punctate26.48041.04955No
